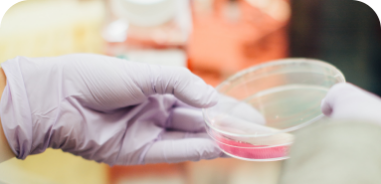

Professor Garrard is a neurologist with over thirty years of clinical experience, and special expertise in the diagnosis and treatment of cognitive disorders. His research focuses on language change in neurological disorders.
Welcome to CogEleven
A private medical consultancy for neurological conditions, focusing on cognitive disorders including Alzheimer’s disease and other causes of dementia.
Designed for private medical and medicolegal consultations, we specialise in neurological illnesses, and cognitive disorders, offering advanced care for a range of conditions, including Alzheimer’s disease.
At CogEleven, expert opinion is based on comprehensive clinical evaluation and the latest diagnostic technology.

Initial clinical evaluations last for an hour, at the end of which you receive a provisional diagnosis or a range of possible diagnoses.
Our partners at Wimbledon Neurocare, Oryon Imaging, The London Clinic and The Doctors’ Laboratory are among the top-rated services that we use to help us to reach an accurate diagnosis.

We prepare expert reports for civil or criminal court proceedings, and to assist lawyers to understand complex medical scenarios.

A medical expert witness report is an impartial document created by a qualified and experienced medical professional, such as a Consultant or specialist health professional, which provides an analysis of the medical facts relevant to a case. Medico-legal reports are typically requested by UK solicitors during legal proceedings.
Explore which option is right for you to book your first visit with Professor Peter Garrard who has decades of experience specialising in clinical and cognitive neuroscience.
Access the symptom questionnaires that CogEleven has developed to enhance clinical cognitive evaluation.
Professor Garrard is a neurologist with over thirty years of clinical experience, and special expertise in the diagnosis and treatment of cognitive disorders. His research focuses on language change in neurological disorders.
Tara provides administrative and secretarial support to Professor Peter Garrard, including ordering supplies, preparing medical records, and scheduling appointments.